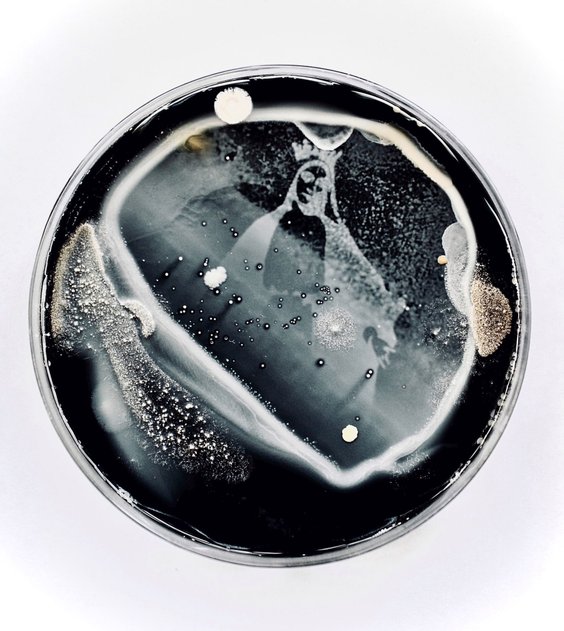

W Krakowie na początku grudnia otwarto indywidualną wystawę Living Images, prezentującą prace Agaty Kuziak, tworzącej w nurcie bioart. Artystka, która z wykształcenia jest mikrobiologiem, realizuję projekty z pogranicza sztuki i biologii. Wykorzystuje autorską technikę, aplikując różnego rodzaju pożywki mikrobiologiczne w hodowli grzybów i drobnoustrojów. Wyhodowane materiały utrwala, stosując podstawowe techniki laboratoryjne, a także naświetlając promieniami UV i wykorzystując grafikę rastrową do uzyskania żywych obrazów. Na wernisażu wystawy autorka prezentowała szalki Petriego schowane pod szklanymi kopułami.
Czytaj więcej
Sprawdzamy, którzy artyści najlepiej się sprzedają. Malarstwo młodych to niestety często „disco polo na palecie".
Jak wskazuje, inspiracją do pracy twórczej są rzeczy niewidzialne, ale równocześnie obecne w otaczającym nas świecie nawet wtedy, gdy nie zdajemy sobie z tego sprawy. – Podstawowym zastosowaniem światła UV jest neutralizacja drobnoustrojów, a w technikach stosowanych przeze mnie jest narzędziem regulującym wzrost. Po wielogodzinnych próbach dopracowania warsztatu twórczego i standaryzacji metodyki uzyskałam efekt, którym mogę się podzielić zarówno z przyrodnikami, jak i odbiorcami z wrażliwością na estetykę – mówi Kuziak.

Saccharomyces cerevisiae na podłożu Sabourauda z węglem aktywnym, 60x40
Jak wskazuje, trudności w procesie twórczym jest wiele, gdyż ma do czynienia z żywymi organizmami, które rządzą się swoimi prawami.
– Czuję jednak ogromną radość z możliwości dzielenia się moimi pracami z odbiorcami, których interpretacja jest dodatkowym komentarzem do fotografii – dodaje. Artystka jest asystentem w Zakładzie Mikrobiologii Farmaceutycznej CMUJ w Krakowie. Swoje prace po raz pierwszy prezentowała w Salzburgu podczas spotkania dla młodych naukowców i artystów w ramach projektu Roche Continents, a także promując działalność naukowo-artystyczną na stronie internetowej Instytutu Farmakologii im. Jerzego Maja PAN w Krakowie. Wystawa jej prac w krakowskim Pierwszym Lokalu na Stolarskiej po lewej stronie, idąc od Małego Rynku, potrwa do końca grudnia.







